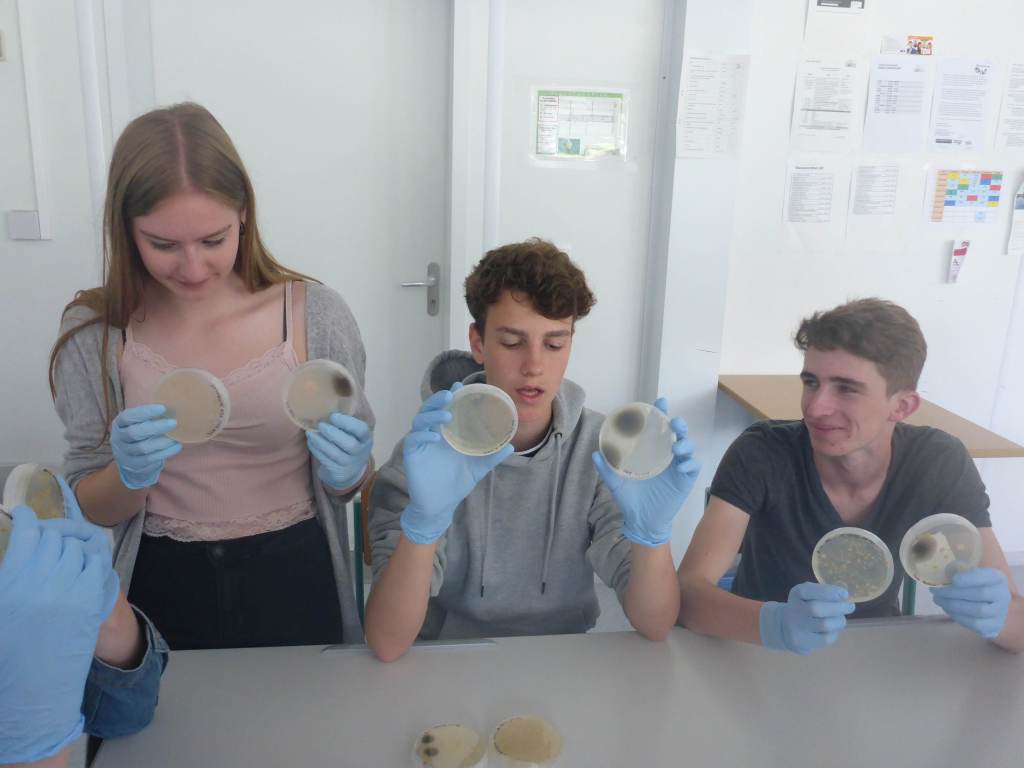

Am 23. Mai war das Projektteam wieder am BORG Oberndorf zu Gast. Zunächst gab es einen Vortrag zur Bedeutung der Bakterien. Wer hätte gedacht, dass Vorfahren der heute lebenden Bakterien die Photosynthese ‚erfunden‘ haben. Diese Erfindung ermöglicht das Leben auf der Erde, wie wir es heute kennen. Das Leben in unseren Gewässern wäre ohne Bakterien nicht möglich, da Abgestorbenes und Ausgeschiedenes nicht abgebaut würde. Auch wir könnten ohne unsere Darmbakterien und Hautbakterien nicht leben.
Dann begann der interessantere praktische Teil 😉 . Zunächst wurden die Agarplatten vom ersten Workshop angeschaut. Die meisten hatten mit ihren Vermutungen recht gehabt. Im Vorlauf aus der Schnapsbrennerei sind tatsächlich keine Bakterien, in Leitungswasser dagegen eine ganze Menge und die dürfen dort auch sein. Am erstaunlichsten war eine Probe von einem Pool. Keine einzige Bakterienkolonie war auf den Platten gewachsen 😉 .

Aber das wichtigste war, die mitgebrachten Gewässerproben zu bearbeiten. Die Proben wurden zunächste filtriert, da die kleinen Bakterien meist die interessanteren sind. Dann legte jeder vier Agarplatten mit unterschiedlicher Nährstoffzusammensetzung mit seiner Probe an. Das Projektteam wird die Platten nun weiter bearbeiten und wir werden sehen, ob sich interessante Bakterien davon isolieren lassen.













